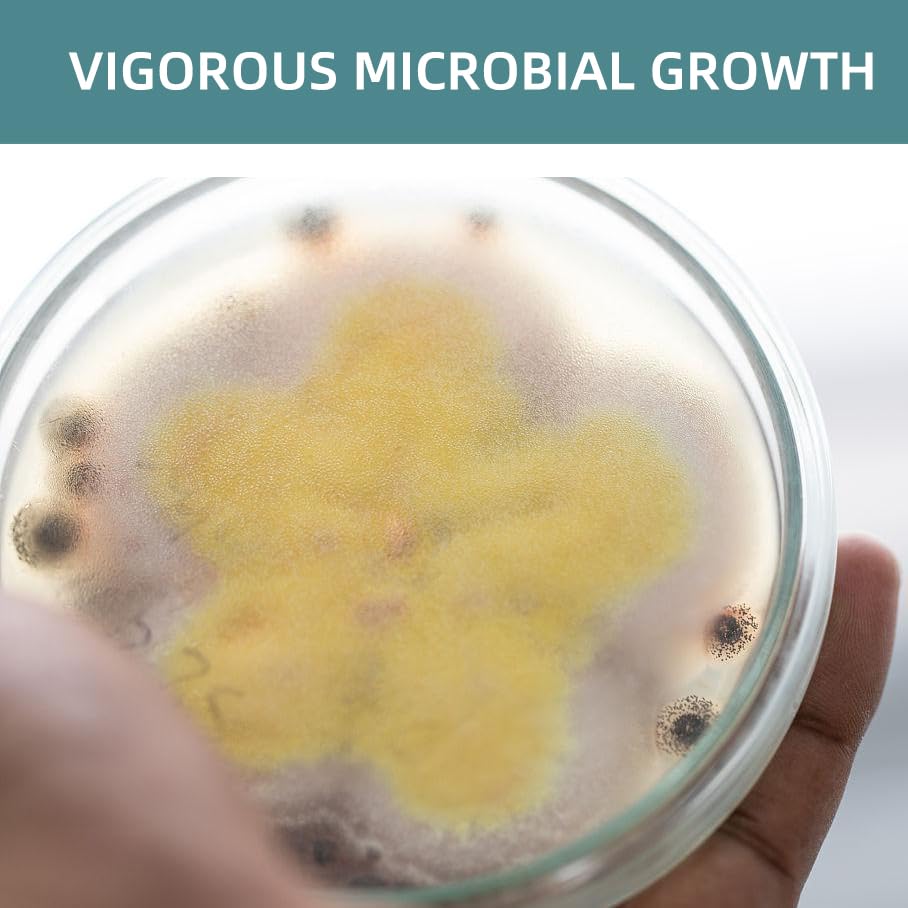
142 Grams Nutrient Agar Powder, Makes Over 210 To 280 Agar Petri Dishes, Easy To Use, Suitable For Scientific Research, Educatio

You will not be allowed to compare more than 4 products at a time
View compareFrequently Asked Questions
- Q: What is the size of the Nutrient Agar Powder package? A: The Nutrient Agar Powder package contains five ounces of product, suitable for making numerous agar petri dishes.
- Q: How many agar petri dishes can I make with this product? A: You can make over two hundred to two hundred eighty agar petri dishes with this nutrient agar powder.
- Q: Is there any specific material used in this agar powder? A: The Nutrient Agar Powder is composed of various nutrients suitable for microbial culture, but specific ingredients are not listed.
- Q: What type of experiments can I use this agar for? A: This nutrient agar powder is suitable for scientific research, educational experiments, and detection of microbial pollutants.
- Q: Can I use this product for educational purposes? A: Yes, this product is ideal for educational experiments, allowing students to explore microbiology concepts.
- Q: Is this Nutrient Agar Powder easy to use? A: Yes, it is designed for ease of use, making it accessible for both beginners and experienced users.
- Q: How do I prepare the agar using this powder? A: To prepare the agar, mix the powder with water according to the instructions provided on the package and then sterilize.
- Q: Is this product suitable for children to use? A: Yes, it can be used for educational purposes under adult supervision, making it suitable for children.
- Q: What is the best way to store the Nutrient Agar Powder? A: Store the Nutrient Agar Powder in a cool, dry place to maintain its quality and effectiveness.
- Q: Does this agar powder have a shelf life? A: Yes, the Nutrient Agar Powder has a shelf life, and it is recommended to use it before the expiration date on the package.
- Q: Can I return this product if I'm not satisfied? A: Yes, there is typically a return policy in place; check with the seller for specific return guidelines.
- Q: What do I do if the agar doesn't set properly? A: If the agar doesn't set, ensure the correct temperature was maintained during preparation and verify the mixing ratio.
- Q: Is this agar powder suitable for professional laboratory use? A: Yes, it is suitable for scientific research and professional laboratory applications.
- Q: Can I use this agar for growing specific types of bacteria? A: Yes, Nutrient Agar is versatile and can support the growth of a wide range of bacteria.
- Q: Is this product safe for the environment? A: Yes, the ingredients in Nutrient Agar Powder are generally considered safe for the environment when disposed of properly.
- Q: What happens if the product arrives damaged? A: If the Nutrient Agar Powder arrives damaged, contact the seller to address the issue and seek a replacement.